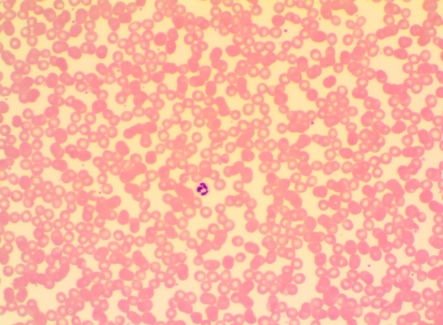
<p>What is this</p>

A&P LAB exam 1
1/70
There's no tags or description
Looks like no tags are added yet.
Name | Mastery | Learn | Test | Matching | Spaced | Call with Kai |
|---|
No analytics yet
Send a link to your students to track their progress
71 Terms

What is this
Simple Squamous Epithelium

what is this
Simple Cuboidal Epithelium

What is this
Simple Columnar Epithelium

What is this
Pseudostratified Columnar Epithelium

What is this
Stratified Squamous Epithelium

What is this
Transitional Epithelium

What is this
Loose Fibrous Connective Tissue

What is this
Adipose Loose Fibrous Connective Tissue

What is this
Reticular Loose Fibrous Connective Tissue

What is this
Dense Irregular Fibrous Connective Tissue

What is this
Dense Regular Fibrous Connective Tissue

What is this
Dense Elastic Fibrous Connective Tissue

What is this
Fibrocartilage Connective Tissue

what is this
Hyaline Cartilage Connective Tissue

What is this
Elastic Cartilage Connective Tissue

What is this
Bone Connective Tissue (Compact)
What is this
Blood Connective Tissue

What is this
Skeletal Muscle

What is this
Smooth Muscle

What is this
Cardiac Muscle

What is this
Nerve Tissue
What are the 4 main types of tissue?
Epithelium, Connective, Muscle, and Nerve
What does the integumentary system include
Hair, skin, nails, and various glandular structures
Order of Epidermis (Deep → Superficial)
Stratum Basale → Stratum Spinosum → Stratum Granulosum → Stratum Lucidum → Stratum Corneum
What’s different about the Stratum Corneum
very thick layer of dead cells
What’s different about the Stratum Basale
Mitotically active layer
What’s different about the Stratum Spinosum
Contains Dendritic (Langerhans) cells for Immunity
What’s different about the Stratum Lucidum
Only in palms of hands & soles of feet
what does the Sudoriferous gland produce
sweat (eccrine)
What does the sebaceous gland produce
oil (holocrine)
Does the scalp have Stratum Lucidum
NO
What is the only layer on the hands and feet
Stratum Lucidum

What is this
Stratum Corneum

What is this
Stratum Spinosum

What is this
Stratum Basale

What is this
Stratum Lucidum

What is this
Stratum Granulosum

What is this
Stratum Corneum

What is this
Stratum Lucidum

What is this
Stratum Granulosum

What is this
Stratum Spinosum

What is this
Stratum Basale

What is this
Fair shaft

What is this
Sudoriferous gland

What is this
Hair bulb

What is this
Sebaceous Gland

What is this
Hair root

What is this
Arrector pilli muscle

What is this
Epidermis

What is this
Dermis

What is this
Hypodermis

What is this
Apocrine Sudoriferous Gland

What is this
Eccrine sudoriferous gland

What is this
Sebaceous Gland

What is this
Hair root

What is this
Hair Shaft

What is this
Meissner’s corpuscle

What is this
Arrector Pili muscle

What is this
Ruffini Endings

What is this
Pacinian Corpuscle

What is this
Apocrine sudoriferous gland

What is this
Eccrine Sudoriferous gland

What is this
Sebaceous Gland

What is this
Papillary layer of Dermis

What is this
Reticular layer of dermis

What is this
Meissner’s corpuscle

What is this
Pacinian corpuscle

What is this
Adipose tissue

What is this
Blood vessels

What is this
Stratum Lucidum

What is this
Thick stratum corneum